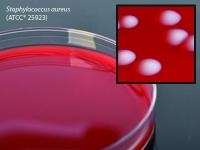

Medium Columbia Agar 15x100mm Pltd , Pack Of 10
$ 45.62
|
|
Details:
Columbia Agar Plate 10Pk^ ColUmbia Agar, 15x100mm plate, order by the package of 10, by Hardy Diagnostics
Additional Information
| SKU | 23339034 |
|---|---|
| UOM | Pack of 10 |
| UNSPSC | 41106212 |
| Manufacturer Part Number | G250 |
| Product Dimensions | 4X4X8 Inches |
| Product Weight | 0.8 |
